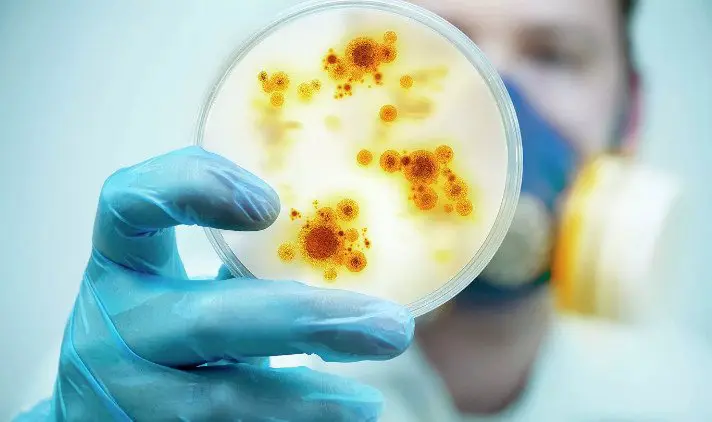

Команда российских специалистов из Южно-Уральского государственного университета (ЮУрГУ) совместно с Институтом органической химии РАН и международными коллегами совершила важный научный прорыв — они разработали новый путь создания перспективных химических соединений, способных эффективно бороться с инфекциями, вызванными бактериями и грибками.
Проблема устойчивости и новые вызовы медицинской химии
Сегодня, несмотря на значительный арсенал современных антибиотиков и противогрибковых средств, мировое научное сообщество сталкивается с нарастающей проблемой устойчивости патогенов к существующим препаратам. Постепенное снижение эффективности традиционных лекарств вынуждает химиков и фармакологов искать инновационные решения, способные справиться с новыми штаммами бактерий и грибков, угрожающих человеческому здоровью.
Уникальная стратегия синтеза гетероциклических азолов
В ходе исследований ученые обратили внимание на гетероциклические азолы — класс соединений, который ранее был недостаточно изучен с точки зрения антимикробной активности. Российские специалисты смогли усовершенствовать методику селективной замены атомов серы на селен, что позволило синтезировать новый ряд уникальных молекул — 1,2,3-тиаселеназолов. Этот инновационный подход лежит в основе создания новых классов соединений, где в структуре органических молекул соседствуют атомы селена и серы, что ранее практически не встречалось в научной практике.
Профессор ЮУрГУ Олег Ракитин, сыгравший ключевую роль в разработке этой технологии, подчеркивает: открытая реакция замещения серы на селен открыла перед исследовательской группой новые горизонты в дизайне препаратов для медицинской химии.
Широкий потенциал 1,2,3-тиаселеназолов для борьбы с инфекциями
Особый интерес вызвали отдельные производные 1,2,3-тиаселеназола, которые в ходе тестирования продемонстрировали низкую токсичность при высоких показателях антимикробной активности даже в небольших концентрациях. Эти вещества показали значительную эффективность против широкого спектра патогенных микроорганизмов — в том числе опасных штаммов бактерий, таких как золотистый стафилококк, а также ряда агрессивных грибков.
Исследования указывают на большой терапевтический потенциал новых соединений: в дальнейшем они могут использоваться не только как средства борьбы с классическими бактериальными или грибковыми инфекциями, но и стать основой для препаратов, действующих против вирусов, ВИЧ и даже онкологических заболеваний. Согласно словам профессора Ракитина, универсальность открытых веществ позволит разрабатывать лекарства для пациентов с различными иммунными и инфекционными патологиями.
Оптимизация структур и дальнейшие перспективы
Сегодня работа научных коллективов продолжается: исследователи проводят поиск и анализ наиболее эффективных молекулярных структур — с максимальным значением терапевтического индекса для каждой конкретной группы заболеваний. Это позволяет надеяться, что в обозримом будущем медицинская практика получит новые препараты, способные преодолеть существующую резистентность патогенных микроорганизмов и расширить спектр терапии инфекционных болезней.
Помимо этого, команда ЮУрГУ и Института органической химии РАН планирует продолжить синтез и изучение новых производных 1,2,3-тиаселеназолов, а также исследовать возможности этих соединений для борьбы с вирусными заболеваниями и другими состояниями, где требуется высокоселективное воздействие на патогены.
Важность междисциплинарного и глобального научного сотрудничества
Успех исследования, в котором приняли участие как российские ученые, так и специалисты из других стран, свидетельствует о высокой значимости объединения усилий мирового научного сообщества для решения острых проблем современной медицины. Оптимизм, с которым участники говорят о результате, подкреплен реальными успехами в лабораторных испытаниях, а достижение российских химиков открывает новые перспективы для разработки эффективных лекарств как в стране, так и на международном уровне.
Таким образом, Южно-Уральский государственный университет и Институт органической химии РАН продемонстрировали возможность принципиально нового подхода к борьбе с устойчивыми инфекциями, вкладывая значительный вклад в развитие инновационной медицинской химии.
Источник: scientificrussia.ru





